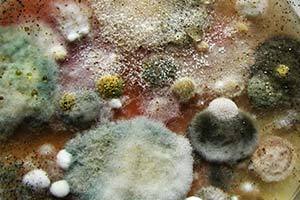

Устраним неприятные запахи, плесень, насекомых и грызунов за 15 минут.
Пройдите короткий тест, чтобы узнать стоимость услуги по озонированию помещения

Выезд специалиста в день обращения
Тест, чтобы узнать стоимость услуги по озонированию помещения
Спасибо за заявку! Наш менеджер свяжется с Вами в ближайшее время
Заявка на обратный звонок
Даю согласие на обработку персональных данных
Заполните форму. Наш специалист свяжется с Вами в ближайшее время.
Даю согласие на обработку персональных данных
ДОБРО ПОЖАЛОВАТЬ
Специалисты нашей компании проводят озонирование жилых, производственных, офисных помещений, мест общественного питания, спортзалов, фитнес-клубов, школьных-дошкольных учреждений и автотранспорта.
Устраняем неприятные запахи любого происхождения, дезинфицируем и стерилизуем, удаляем грибки и плесень, уничтожаем насекомых и избавляем от грызунов. 100% результат без применения химии. Доказано учеными, подтверждено людьми.
Устраняем неприятные запахи любого происхождения, дезинфицируем и стерилизуем, удаляем грибки и плесень, уничтожаем насекомых и избавляем от грызунов. 100% результат без применения химии. Доказано учеными, подтверждено людьми.
НАШИ УСЛУГИ
More products
Необходимо решить сразу комплекс проблем?
Узнайте как быстро и эффективно сделать это при помощи озонирования
Что такое озонирование?
Озонирование - экологически чистая технология очистки воздуха и поверхностей, основанная на использовании газа озона - мощного окислителя. Озон вырабатывается из кислорода, который содержится в атмосферном воздухе и после взаимодействия с загрязняющими химическими и микробиологическими веществами, быстро переходит в обычный кислород. Практикой доказано, что все продукты озонирования безвредны для человека и животных.Подходит всем: аллергикам, астматикам, грудничкам и т.д.
Технология озонирования позволяет нам быстро и качественно, проводить дезинфекцию в помещениях различного типа и автотранспорте, устранить любой неприятный запах (не применяя хлорсодержащих средств!), уничтожить насекомых (без использования инсектицидов), эффективно удалить плесень и её споры в воздухе, снизить действие токсичных веществ, а также нейтрализовать ртуть в помещении и убрать ядовитые ртутные пары!
Технология озонирования позволяет нам быстро и качественно, проводить дезинфекцию в помещениях различного типа и автотранспорте, устранить любой неприятный запах (не применяя хлорсодержащих средств!), уничтожить насекомых (без использования инсектицидов), эффективно удалить плесень и её споры в воздухе, снизить действие токсичных веществ, а также нейтрализовать ртуть в помещении и убрать ядовитые ртутные пары!
ПРЕИМУЩЕСТВА ОЗОНИРОВАНИЯ:

В природе нет форм вирусов, бактерий и микробов устойчивых к озону

Озон начинает действовать в течение нескольких секунд

Озон проникает во все труднодоступные места и скрытые полости

После обработки озоном в помещении не нужна уборка! Все поверхности и предметы в помещении становятся полностью стерильными.

Остаточный озон быстро превращается в кислород и становится безвредным

Озон по своим свойствам в 300-3000 раз мощнее, чем любые химические средства
НАШИ ПРЕИМУЩЕСТВА
- Мы единственная компания, предоставляющая данную услугу в вашем городе.
- Гарантией качества услуг выступают наши специалисты, прошедшие подготовку и имеющие стаж работы с озоном от 3х лет.
- В работе мы используем промышленные озонаторы воздуха мощностью от 15 до 100 гр/ч, способные обработать помещения любой площади.
- Мы всегда готовы к решению самых сложных задач.
- Выезд специалиста в день обращения.
ВИДЕО-ОТЗЫВЫ НАШИХ КЛИЕНТОВ
ОТЗЫВЫ НАШИХ КЛИЕНТОВ
- НАТАЛЬЯ КАЛИНИНА«Хотела бы оставить отзыв о вашей услуге озонирование , впервые услышала об озоне от знакомых , года два назад ( они воспользовались вашей услугой после пожара в подвале ) и я решила воспользоваться от запаха в квартире после ремонта . Мне очень понравилось обслуживание , вежливый мастер , все объяснил по телефону, договорились о времени. После обработки квартиры не осталось запаха. Желаем вам процветания успехов в вашем деле.»
- ВЕРОНИКА ПОПОВА«Заказывала услугу -озонирования машины , был едкий запах сигарет в машине в перемешку с духами ( это был ужасный запах ) нашла через группу вконтакте и решила позвонить (вдруг поможет ) позвонила , договорились о встречи. 15 минут обработки в машине озонатором и от запаха ни осталась следа . Я в полном восторге от озонатора . Рекомендую всем .»
- ЭЛЬМИРА МУРЗОМУРАТОВА«Мои родители долгое время не могли избавиться от кошачьего запаха, хотя кошки уже года два как не стало. Решили воспользоваться услугой озонирования - и остались очень довольны! Запах наконец-то исчез навсегда!
Теперь и я пользуюсь бытовым озонатором: озонирую периодически холодильник, теперь там всегда свежо. Да и ребёнок вроде стал меньше болеть после регулярного озонирования воздуха в квартире)» - ВИКТОРИЯ ШУЛЯКОВА«Благодарим Вашу компанию за проведенное озонирование у нас на кухне. Спасибо за оперативную работу, за разъяснительную беседу по проведенной работе. Сотрудник ответственный, честный, эрудированный в своей трудовой сфере. После процедуры в комнате установился нейтральный запах, с последующим исчезновением инородных запахов, что говорит о эффективности проделанной работы. Так же решила приобрести себе бытовой озонатор , незаменимый помощник на кухне»
- ВАСИЛИЙ ТИХОНОВ«Раньше курил в квартире, много и часто, так что запахи въелись в текстиль, диван, шторы. Девушке моей это надоело, она мне поставила ультиматум, чтобы к ее возвращению из поездки запахов не было. Было у меня на это две недели, я подумал само выветрится, но к сожалению все оказалось гораздо сложнее. Совершенно случайно попалось объявление об уничтожении запахов, обработку провели быстро и самое главное эффективно. Запахов нет, девушка со мной, бросаю курить. Спасибо!»